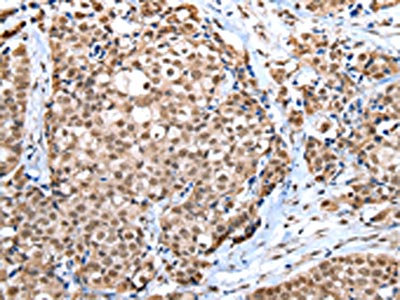

WDR5 Antibody
-
中文名稱:WDR5兔多克隆抗體
-
貨號:CSB-PA062933
-
規(guī)格:¥1100
-
圖片:
-
The image on the left is immunohistochemistry of paraffin-embedded Human breast cancer tissue using CSB-PA062933(WDR5 Antibody) at dilution 1/30, on the right is treated with fusion protein. (Original magnification: ×200)
-
The image on the left is immunohistochemistry of paraffin-embedded Human liver cancer tissue using CSB-PA062933(WDR5 Antibody) at dilution 1/30, on the right is treated with fusion protein. (Original magnification: ×200)
-
Gel: 8%SDS-PAGE, Lysate: 40 μg, Lane 1-2: PC3 and A375 cell, Primary antibody: CSB-PA062933(WDR5 Antibody) at dilution 1/350 dilution, Secondary antibody: Goat anti rabbit IgG at 1/8000 dilution, Exposure time: 5 seconds
-
-
其他:
產(chǎn)品詳情
-
Uniprot No.:
-
基因名:WDR5
-
別名:2410008O07Rik antibody; AA408785 antibody; AA960360 antibody; BIG 3 antibody; Big antibody; BIG3 antibody; BMP2 induced 3 kb gene protein antibody; BMP2 induced gene; 3-KB antibody; BMP2-induced 3-kb gene protein antibody; MGC114572 antibody; OTTHUMP00000162494 antibody; SWD 3 antibody; SWD3 antibody; SWD3 Set1c WD40 repeat protein homolog antibody; WD repeat containing protein 5 antibody; WD repeat domain 5 antibody; WD repeat protein 5 antibody; WD repeat-containing protein 5 antibody; WD repeat-containing protein BIG-3 antibody; WDR 5 antibody; Wdr5 antibody; WDR5_HUMAN antibody
-
宿主:Rabbit
-
反應種屬:Human,Mouse,Rat
-
免疫原:Fusion protein of Human WDR5
-
免疫原種屬:Homo sapiens (Human)
-
標記方式:Non-conjugated
-
抗體亞型:IgG
-
純化方式:Antigen affinity purification
-
濃度:It differs from different batches. Please contact us to confirm it.
-
保存緩沖液:-20°C, pH7.4 PBS, 0.05% NaN3, 40% Glycerol
-
產(chǎn)品提供形式:Liquid
-
應用范圍:ELISA,WB,IHC
-
推薦稀釋比:
Application Recommended Dilution ELISA 1:2000-1:5000 WB 1:500-1:2000 IHC 1:25-1:100 -
Protocols:
-
儲存條件:Upon receipt, store at -20°C or -80°C. Avoid repeated freeze.
-
貨期:Basically, we can dispatch the products out in 1-3 working days after receiving your orders. Delivery time maybe differs from different purchasing way or location, please kindly consult your local distributors for specific delivery time.
-
用途:For Research Use Only. Not for use in diagnostic or therapeutic procedures.
相關產(chǎn)品
靶點詳情
-
功能:Contributes to histone modification. May position the N-terminus of histone H3 for efficient trimethylation at 'Lys-4'. As part of the MLL1/MLL complex it is involved in methylation and dimethylation at 'Lys-4' of histone H3. H3 'Lys-4' methylation represents a specific tag for epigenetic transcriptional activation. As part of the NSL complex it may be involved in acetylation of nucleosomal histone H4 on several lysine residues. May regulate osteoblasts differentiation. In association with RBBP5 and ASH2L, stimulates the histone methyltransferase activities of KMT2A, KMT2B, KMT2C, KMT2D, SETD1A and SETD1B.
-
基因功能參考文獻:
- WDR5 was identified as a substrate of SETD6 and it was revealed that the methylation of specific lysines (K207/K325) of WDR5 was critical for maintaining global histone H3K4me3 levels and promoting breast cancer cell proliferation and migration PMID: 30226578
- WDR5 is aberrantly overexpressed in head neck squamouos cell carcinoma and associates with aggressiveness and unfavorable prognosis, thus representing a novel diagnostic and prognostic biomarker for the cancer. PMID: 29569374
- This is the first demonstration of the mechanism of E2/ERalpha signalling activation via the BIG3-PKA-PP1Calpha tri-complex in breast cancer cells. PMID: 28555617
- Data found that the expression of WDR5 increased in a majority of the human gastric cancer tissues. Its knockdown significantly inhibited the ability of cell proliferation, reversed cell cycle arrest as well as cell's tumorigenicity. Data reveal that WDR5 may have oncogenic effect and WDR5-mediated H3K4 methylation plays an important role in gastric cancer. PMID: 29125890
- findings reveal a nongenomic function for WDR5 in regulating H3K4 methylation induced by 3D environments, physical properties of the nucleus, cell polarity, and cell migratory capacity. PMID: 29987046
- HCMV infection increases protein levels of WD repeat-containing protein 5 (WDR5) during infection, overexpression of WDR5 enhances viral replication, and knockdown of WDR5 dramatically attenuates viral replication. The results indicate that WDR5 promotes the nuclear egress of viral capsids, the depletion of WDR5 resulting in a significant decrease in production of infectious virions. PMID: 29437978
- our findings indicate that HOXD-AS1 promotes proliferation, castration resistance, and chemo-resistance in prostate cancer by recruiting WDR5. PMID: 28487115
- Functional analysis implicates TNRC6A, NAT10, MED14, and WDR5 in RNA-mediated transcriptional activation. PMID: 28813667
- The decrease in WDR5 expression was particularly evident in HD-hiPSCs compared to hESCs and control-hiPSCs from healthy subjects PMID: 28476540
- we demonstrate for the first time that targeted expression of miR-31-5p using a nonviral minicircle vector can serve as a novel approach for tumor miRNA therapy. Moreover, WDR5 may be a promising therapeutic target for NPC treatment. PMID: 28042945
- WDR5 may have oncogenic effect and WDR5-mediated H3K4 methylation plays an important role in leukemogenesis PMID: 27192115
- WDR5 functions to sustain proper execution of DNA replication in pancreatic ductal adenocarcinoma cells, as previously suggested by replication stress studies involving MLL1, and c-Myc, also found to interact with WDR5. PMID: 27320920
- This report documents a novel lncRNA, GClnc1, which may act as a scaffold to recruit the WDR5 and KAT2A complex and modify the transcription of target genes. This study reveals that GClnc1 is an oncogenic lncRNA in human gastric cancer. PMID: 27147598
- different cancer mutations in MLL1 lead to a loss or increase in activity, illustrating the complex and tumor-specific role of MLL1 in carcinogenesis. PMID: 28182322
- WDR5 shows a direct binding to the ZNF407 promoter. PMID: 28300833
- Taken together, these data suggest that WDR5 is directly involved in p53 signaling pathway. Our studies provide a new insight into WDR5 functions in A549 cells. PMID: 28412363
- Targeted Disruption of the Interaction between WD-40 Repeat Protein 5 (WDR5) and Mixed Lineage Leukemia (MLL)/SET1 Family Proteins Specifically Inhibits MLL1 and SETd1A Methyltransferase Complexes. PMID: 27563068
- WDR5 over-expression is associated with poor breast cancer clinical outcome. PMID: 26355959
- Results identify WDR5 as a key cofactor for N-Myc-regulated transcriptional activation and tumorigenesis and as a novel therapeutic target for MYCN-amplified neuroblastomas. PMID: 26471359
- BIG3 may block the KPNAs (KPNA1, KPNA5, and KPNA6) binding region(s) of PHB2. PMID: 26052702
- solution structures of the MLL3 core complex assembled with and without WDR5 by small angle x-ray scattering show similar overall topologies PMID: 26324722
- Target gene recognition by MYC depends on its interaction with WDR5. This interaction could create an avidity-based chromatin recognition mechanism allowing MYC to select its target genes in response to both genetic and epigenetic determinants. Review. PMID: 26383167
- we have discovered that WDR5 plays an important role in bladder cancer suggesting that WDR5 is a potential biomarker and a promising target in the treatment of bladder cancer. PMID: 25656485
- Wdr5-MLL interaction in C/EBPA N-terminal leukemia is a promising pharmacological target. PMID: 26167872
- findings prove that the TSP-1/CD47/SIRP-alpha signal axis is important to the evolution of tumor cells in the microenvironment of immunotherapy and identify thrombospondin-1 as a key signal PMID: 25666610
- results identify WDR5 as a critical epigenomic integrator of histone phosphorylation and methylation and as a major driver of androgen-dependent prostate cancer cell proliferation PMID: 24793694
- BIG3(WRD5)-PHB2 interaction is critical for the tamoxifen resistance of breast cancer cells; its targeting reverses the resistance. PMID: 24051437
- Data indicate that MLL1 methylates Ash2L in the absence of histone H3, but only when assembled within a complex with WDR5 and RbBP5. PMID: 24235145
- data are consistent with a model in which WDR5 binds the gamma-globin promoter in a PRMT5-dependent manner. PMID: 22689669
- A small molecule antagonist binds to WDR5 in the peptide-binding pocket which inhibits the catalytic activity of mixed-lineage leukemia protein. PMID: 22989411
- we defined a role for Trithorax proteins WDR5 and MLL2 in activating the differentiation gene program in epidermal progenitor cells PMID: 22829784
- WDR5-Win motif interaction is important for the assembly of the MLL1 core complex in vivo. PMID: 22665483
- findings show that WDR5 is a direct target of SRY; the interaction of WDR5 and SRY activates Sox9 expression; results suggest that, in conjunction with SRY, WDR5 plays an important role in sex determination PMID: 22523547
- WDR5 as a critical substrate of CUL4B in regulating neuronal gene expression. PMID: 21816345
- crystal structure of WDR5 in ternary complex with RbBP5 and MLL1 PMID: 21220120
- the change of folding free energy by mutations mainly corresponds to the deletion of hydrogen bonds. PMID: 20939513
- NSL is composed of nine subunits. Two of its subunits, WD repeat domain 5 (WDR5) and host cell factor 1 (HCF1), are shared with members of the MLL/SET family of histone H3 lysine 4 (H3K4) methyltransferase complexes. PMID: 20018852
- Results show that Depletion of CHD8 enhances HOXA2 expression and a loss of the WDR5/Ash2L/RbBP5 subcomplex. PMID: 20085832
- WDR5 is essential in assembling a virus-induced VISA-associated complex and plays an important role in virus-triggered induction of type I interferons. PMID: 20080758
- The WDR5 is required for binding of the methyltransferase complex to the K4-dimethylated H3 tail as well as for global H3 K4 trimethylation and HOX gene activation in human cells. PMID: 15960974
- Wdr5 has a funcitonal role in endocondral bone formation PMID: 16340128
- the high-resolution X-ray structures of WDR5 in the unliganded form and complexed with histone H3 peptides having unmodified and mono-, di- and trimethylated K4 PMID: 16829959
- the crystal structure of WDR5 bound to a histone H3 PMID: 16829960
- WDR5 mediates interactions of the MLL1 catalytic unit both with the common structural platform and with the histone substrate. PMID: 16878130
- involvement of WDR5 in binding and presenting histone H3K4 for further methylation PMID: 16946699
- WDR5's recognition of arginine 3765 of MLL1 is essential for the assembly and enzymatic activity of the MLL1 core complex in vitro PMID: 18829457
- WDR5 recognizes Arg-3765 of MLL1, which is essential for the assembly and enzymatic activity of the MLL1 core complex PMID: 18829459
- analysis of interactions between WDR5, the catalytic subunit, MLL, and the substrate, histone H3, of the MLL complex PMID: 18840606
- The identified components revealed factors involved in histone methylation and cell cycle control and include Ash2L, RbBP5, WDR5, HCF-1, DBC-1, and EMSY. PMID: 19131338
- Activation of an estrogen/estrogen receptor signaling by BIG3 through its inhibitory effect on nuclear transport of PHB2/REA in breast cancer is reported. PMID: 19496786
顯示更多
收起更多
-
亞細胞定位:Nucleus.
-
蛋白家族:WD repeat WDR5/wds family
-
數(shù)據(jù)庫鏈接:
Most popular with customers
-
YWHAB Recombinant Monoclonal Antibody
Applications: ELISA, WB, IHC, IF, FC
Species Reactivity: Human, Mouse, Rat
-
Phospho-YAP1 (S127) Recombinant Monoclonal Antibody
Applications: ELISA, WB, IHC
Species Reactivity: Human
-
-
-
-
-
-